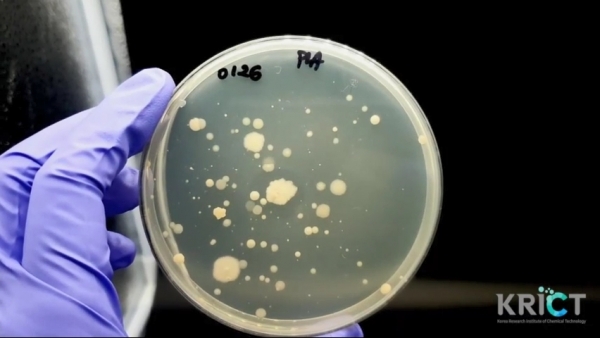
플라스틱 분해 미생물 스크리닝 키트 속 미생물이 플라스틱을 갉아먹은 모습 / 화학연 제공

플라스틱 분해 미생물을 쉽고 빠르게 찾아낼 수 있는 키트가 국내 연구진에 의해 개발됐다.
한국화학연구원은 해당 미생물을 3일에서 1주일 안에 빠르게 찾아낼 수 있는 키트를 개발하고, 특허출원을 완료했다고 13일 밝혔다. 해당 연구는 국제학술지 ‘Green Chemistry’에 게재됐다.
이번에 개발된 스크리닝 키트는 화학연 오동엽·신기영 박사팀이 개발했다.
키트는 손바닥 크기의 둥근 샬레로, 빈 샬레에 미생물이 살 수 있는 얇은 땅(배지)을 깔고, 그 위에 플라스틱을 녹인 용액을 스프레이로 뿌려 마이크로 사이즈로 코팅한다.
그 후 강물이나 해수, 흙탕물 등을 뿌리면 특정 미생물들이 플라스틱 코팅된 부분을 먹어치운다. 플라스틱이 없어지면 배지만 드러나 색이 투명해지는데, 그 부분을 도구로 긁어 채취하는 방식이다.
이 모든 과정은 일주일 안에 끝난다. 플라스틱을 작은 크기인 직경 20 마이크로 미만의 사이즈로 코팅했기 때문에 표면적이 넓어 미생물이 빠르게 분해할 수 있기 때문이다. 또 플라스틱을 영양분으로 삼은 미생물이 짙은 농도로 번식하고 생장하는 것을 육안으로 확인할 수 있어 추출도 간편하게 할 수 있다.
연구팀은 키트를 통해 플라스틱 필름을 분해할 수 있는 미생물을 하수 처리장 및 토양으로부터 3일 이내에 추출해냈다. 추출한 미생물을 배양한 곳에 1cmx1cm 면적의 100마이크로 두께 필름을 넣으면 2주 안에 분해되는 것을 확인했다.
연구팀은 키트를 활용해 플라스틱 분해 미생물 균주를 다양하게 확보하고 대량생산하기 위한 연구를 진행할 계획이다. 또 생분해 플라스틱 제조 기술에도 활용할 예정이다.
오동엽 박사는 “플라스틱 자연 분해는 미생물을 대량으로 생산하는 공정, 유통하고 공급하는 과정 등이 선행되어야 하기 때문에 당장 상용화되기는 어렵다”면서도 “하지만 기후변화가 심각해지고 있어 향후 플라스틱 분해 미생물들의 가치가 높아질 것으로 예상한다”고 전망했다.
이어 “해외 연구실들은 플라스틱 분해 미생물 리스트를 외부에 공개하지 않고 국가적 자산으로 확보하고 있다”며 “이 키트가 상용화되면 국내 연구실들이 플라스틱 분해 미생물을 빠르고 쉽게 찾는 데 도움을 줄 수 있을 것”고 설명했다.


